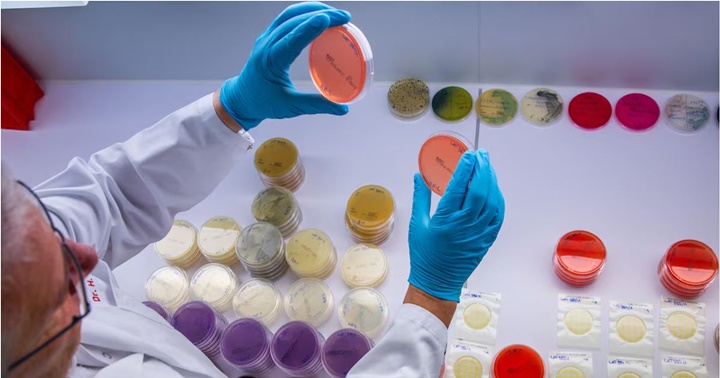

Un estudio desvela los misterios del síndrome de auto fermentación.
Una investigación identifica las bacterias responsables de un raro trastorno que provoca intoxicación sin beber alcohol, y plantea una solución: el trasplante de heces. Un investigador examina unas bacterias en un laboratorio en Alemania.
El oficial retirado de la Marina de EE UU comenzó a experimentar síntomas extraños. A sus 60 años, estaba en una excelente forma física, y solo bebía ocasionalmente alcohol. Pero, tras tomar antibióticos para tratar una inflamación de próstata, comenzó a experimentar episodios extraños: se sentía borracho sin haber probado el alcohol. Desorientación, somnolencia, dificultad para hablar. Los médicos de urgencias no lo creían, y su familia observaba su comportamiento con confusión. Tuvo que instalar un cierre de alcoholímetro en su vehículo, pero ni siquiera él sabía cómo explicar lo que le sucedía.
No estaba loco. Su cuerpo, literalmente, se estaba convirtiendo en una cervecería.
Casos como este estuvieron durante décadas confinados a anécdotas médicas, pero acaban de recibir la validación científica más sólida hasta el momento. Un estudio publicado en Nature Microbiology, realizado por investigadores de la Universidad de California (UC) San Diego y el Hospital General de Massachusetts, ha identificado finalmente qué sucede dentro del intestino de estos pacientes. Y más importante aún, ha encontrado un tratamiento que funciona: el trasplante de heces.
La primera descripción médica del síndrome de autofermentación (ABS, por sus siglas en inglés) se remonta a finales del siglo XIX. Pero durante generaciones, los médicos fueron escépticos. ¿Cómo podía alguien emborracharse sin beber? Y, mientras, se seguían produciendo casos, como el de un hombre belga acusado repetidamente de conducir borracho, y que fue finalmente absuelto porque se demostró que no había bebido ni una gota de alcohol.
En 2019, un artículo revolucionario de investigadores chinos señaló a las bacterias productoras de etanol como las culpables. Pero sin una cohorte grande de pacientes estudiados sistemáticamente, la evidencia seguía siendo anecdótica.
Ahora, los investigadores han estudiado a 22 pacientes con ABS documentado clínicamente, comparándolos con 21 miembros de sus familias sin síntomas, y han revelado la historia de cómo el cuerpo puede fabricar su propio alcohol.
A los pacientes no les cree nadie, ni siquiera sus médicos, explica Bernd Schnabl, gastroenterólogo de la UC San Diego y autor principal del estudio. Cuando alguien llega al hospital intoxicado, es muy fácil asumir que ha estado bebiendo en secreto. Y luego están las consecuencias reales: perder el trabajo, problemas familiares, problemas legales. Esta enfermedad es terrible para las familias, añade. Todo esto hace que sea imposible calcular cuántas personas sufren o han sufrido este síndrome a nivel global.
Pero las historias conocidas impresionan. Una joven que no podía caminar después de recibir glucosa durante una prueba de diabetes de rutina. Pacientes en la treintena, hasta entonces saludables, que comenzaban a experimentar brotes impredecibles de intoxicación severa después de ciertas comidas. En algunos casos, padecían también signos de daño hepático, e incluso uno de los pacientes había desarrollado cirrosis.
El análisis molecular apunta a dos sospechosos principales: Escherichia coli y Klebsiella pneumoniae, bacterias del intestino que, en circunstancias normales, existen en equilibrio con miles de otras especies microbianas. Pero en los pacientes con ABS, ambas se volvieron patógenas: alcanzaban números anormales y, lo más importante, su metabolismo se descontrolaba.
Todos nosotros probablemente producimos pequeñas cantidades de alcohol en nuestros intestinos, porque normalmente tenemos algo de E. coli y K. pneumoniae, explica Schnabl. Pero solo cuando estas bacterias se vuelven excesivamente abundantes, la producción de alcohol alcanza niveles que embriagan al paciente.
En laboratorio, cuando los investigadores cultivaban muestras de heces de pacientes con ABS, las bacterias producían niveles ya medibles de etanol en 24 horas. Las muestras de familiares sanos producían cantidades triviales que el cuerpo metabolizaba fácilmente. En los pacientes enfermos, llegaron a detectarse picos de 136 mg/dl, casi tres veces el límite legal de alcohol para conducir en España.
Bajo la mirada genética, el cuadro se volvió aún más claro. Durante los brotes, el genoma bacteriano estaba enriquecido en genes para la fermentación de etanol: tres vías metabólicas diferentes que las bacterias utilizaban para transformar azúcar en alcohol. Pero durante los períodos de remisión, cuando los pacientes no tenían síntomas, los genes predominantes eran diferentes: aquellos que permiten a otras bacterias metabolizar y eliminar el etanol que se estaba produciendo.
Es como si el cuerpo estuviera en equilibrio durante la remisión, señala Schnabl. Pero durante un brote, ese equilibrio se quiebra.
Antibióticos, culpables
¿Qué provoca que estas bacterias normales se conviertan en patógenas? La evidencia apunta a los antibióticos. El ex marine había tomado múltiples antibióticos para una infección de próstata. Su microbioma intestinal —un ecosistema finamente ajustado de trillones de organismos— fue arrasada. Cuando las bacterias volvieron a crecer, el equilibrio nunca se restauró correctamente. La E. coli y K. pneumoniae regresaron en números desproporcionados, sin las bacterias defensoras que normalmente las mantienen bajo control.
El hombre de Massachusetts, tras años de brotes, se enteró de que existía un grupo de apoyo de pacientes que mencionaba una estrategia radical: trasplantes de microbiota fecal (TMF). En esencia: introducir bacterias de una persona saludable en el intestino del paciente para restaurar el equilibrio perdido.
El paciente contactó con Elizabeth Hohmann, médica en el Hospital General de Massachusetts especializada en trasplantes fecales. Hohmann consultó a Schnabl. Y ambos decidieron intentarlo. Para el tratamiento, Hohmann seleccionó un donante especial: un hombre muy saludable, entrenador personal y gerente de gimnasio. Sus heces fueron procesadas, liofilizadas y envasadas en cápsulas. El paciente tomó múltiples dosis durante varias semanas. Gradualmente, algo notable sucedió. Los síntomas del hombre desaparecieron. Su microbiota se reequilibró. Las bacterias productoras de etanol fueron desplazadas. Dieciséis meses después, permanece en remisión total.
El trasplante fecal funciona, pero Schnabl es claro sobre sus limitaciones: Queremos opciones más dirigidas y, idealmente, más fáciles de implementar que los trasplantes fecales.
Hohmann y Schnabl ya están conduciendo un ensayo clínico más grande en otros pacientes con ABS. El síndrome de autofermentación es extraordinariamente raro. Pero Schnabl señala algo inquietante: el mecanismo subyacente probablemente no lo es. Otros estudios han detectado producción de etanol microbiano a bajo nivel en pacientes con diabetes y enfermedad hepática grasa. Si esos pacientes están constantemente expuestos a cantidades pequeñas de alcohol endógeno, ¿podría eso contribuir al daño hepático? ¿A los problemas de peso? ¿A la resistencia a la insulina?
Todavía no sabemos, admite Schnabl. Pero definitivamente hay razones para investigar estas conexiones.
Lo que sí sabemos ahora es que el síndrome de autofermentación no es un mito. Es real, está causado por bacterias, y es tratable, por ahora, con el supermicrobioma de un entrenador personal.
Patricia Fernández de Lis – El País de España

